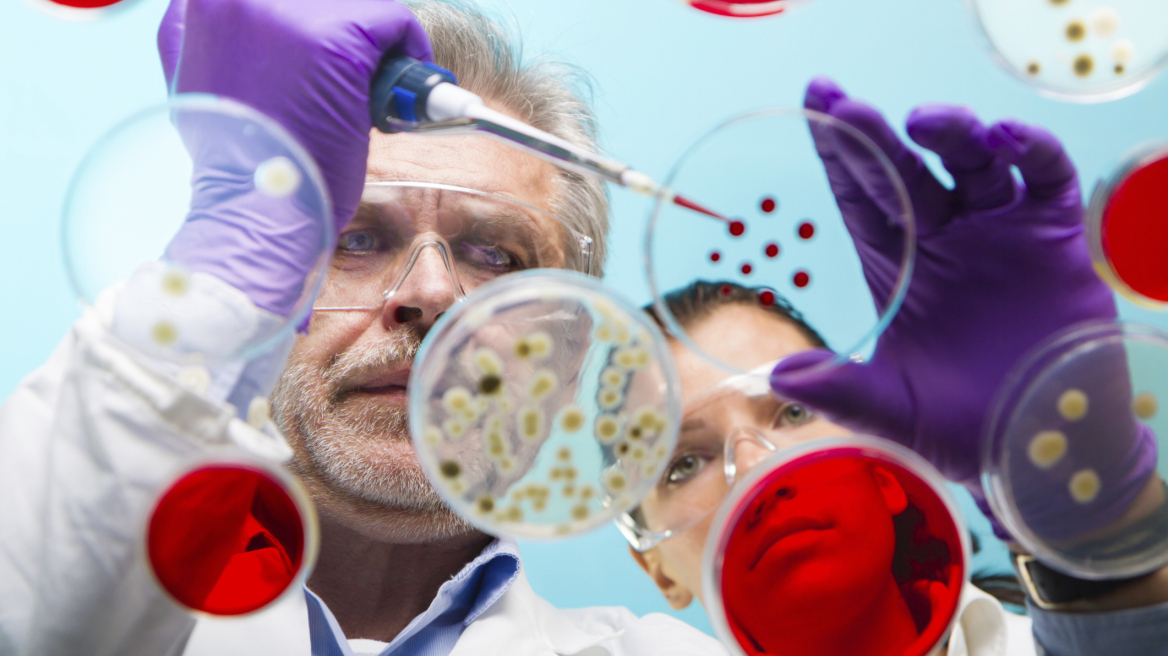
ΠΟΥ: Δύο εμβόλια κατά του Έμπολα θα είναι έτοιμα το Νοέμβριο

Δύο εμβόλια για την πρόληψη της μόλυνσης από τον ιό Έμπολα ενδέχεται να είναι διαθέσιμα τον Νοέμβριο για το προσωπικό των υγειονομικών υπηρεσιών των χωρών εκείνων οι οποίες πλήττονται περισσότερο από την επιδημία στην δυτική Αφρική με πάνω από 2.000 νεκρούς, όπως ανακοίνωσε σήμερα ο Παγκόσμιος Οργανισμός Υγείας (ΠΟΥ).
Μετά τις κλινικές δοκιμές που έχουν γίνει ήδη και αφού ολοκληρωθούν αυτές που έπονται, «εάν τα εμβόλια μοιάζουν ασφαλή, θα μπορούσαν να είναι διαθέσιμα τον Νοέμβριο για χρήση κατά προτεραιότητα από το προσωπικό των υπηρεσιών υγείας», ανέφερε ο ΠΟΥ σε μια ανακοίνωση που εξέδωσε.
Εξάλλου ο Οργανισμός επισήμανε σήμερα ότι προϊόντα που παράγονται με βάση το αίμα επιζώντων του Έμπολα μπορούν να χρησιμοποιηθούν για την αντιμετώπιση του ιού.
Τα υπάρχοντα αποθέματα όλων των πειραματικών φαρμάκων για τον ιό είναι ιδιαίτερα περιορισμένα και δεν θα αρκέσουν ούτε καν για τους επόμενους μήνες, αλλά η κατάσταση όσον αφορά τα εμβόλια μοιάζει να είναι «ελαφρά καλύτερη», ανέφερε ο ΠΟΥ σε ανακοίνωσή του.
Ωστόσο η παροχή επαρκούς κλινικής φροντίδας, η αυστηρή τήρηση των κανόνων για την αποφυγή και τον έλεγχο της μόλυνσης και ο εντοπισμός των προσώπων τα οποία έχουν εκτεθεί στον ιό παραμένουν κρίσιμες παράμετροι για να τερματιστεί η επιδημία η οποία έχει στοιχίσει τη ζωή σε τουλάχιστον 2.097 ανθρώπους από τον Μάρτιο, σύμφωνα με την υπηρεσία αυτή του ΟΗΕ.
«Υπάρχει μια αληθινή ευκαιρία να χρησιμοποιηθούν προϊόντα παράγωγα του αίματος. Αυτό μπορεί να αποδειχθεί πολύ αποτελεσματικό όσον αφορά τη νοσηλεία των ασθενών», δήλωσε η αναπληρώτρια γενική διευθύντρια του ΠΟΥ Μαρί-Πολ Κίνι κατά τη διάρκεια μιας συνέντευξης Τύπου στη Γενεύη.
«Από το αρνητικό δεδομένο ότι έχουμε τόσους πολλούς ασθενείς προκύπτει ένα θετικό, ότι υπάρχουν επίσης πολλοί άνθρωποι που πλέον έχουν αναρρώσει, που επέζησαν και πηγαίνουν καλά. Αυτοί οι άνθρωποι μπορούν να δώσουν αίμα, ορό για να προσφέρουμε νοσηλεία», εξήγησε ο Κίνι. «Ό,τι είναι διαθέσιμο θα χρησιμοποιηθεί επί του πεδίου για να θεραπευτούν ασθενείς το συντομότερο δυνατόν».